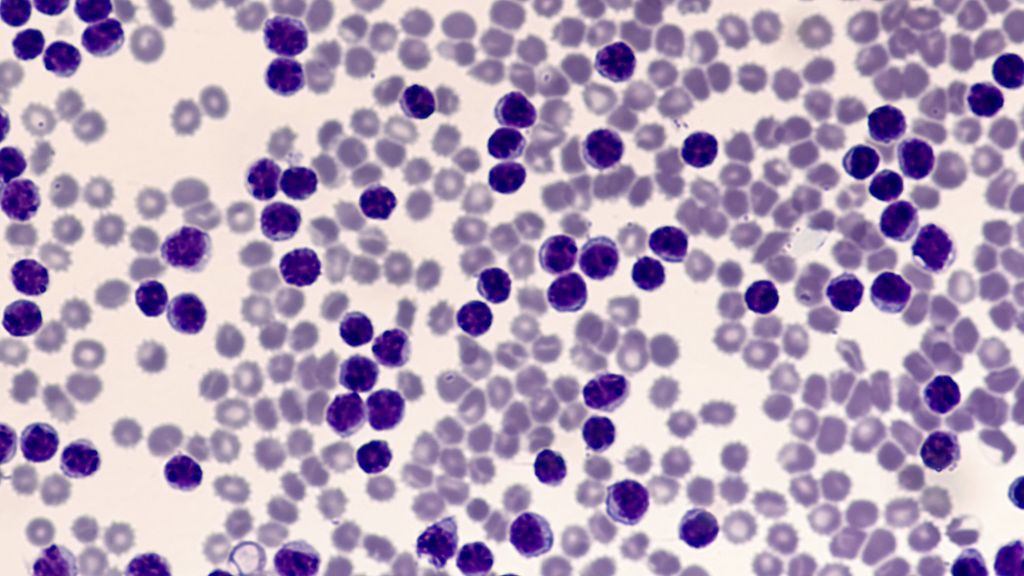

LLC: ibrutinib plus vénétoclax avec durée de traitement adaptée – acalabrutinib en tant que traitement de première intention
Compte-rendu:
Dre Ine Schmale
Lors du 65e congrès annuel de l’American Society of Hematology, de nouvelles données importantes sur la leucémie lymphoïde chronique ont été présentées. Dans le cas de l’association ibrutinib plus vénétoclax, l’influence de la durée individuelle du traitement sur son succès a notamment été étudiée; les résultats étaient prometteurs. Des nouveautés ont également été présentées concernant l’utilisation de l’acalabrutinib, un inhibiteur de la tyrosine kinase de Bruton (BTKi), en tant que traitement de première intention.
Ibrutinib + vénétoclax – la durée individuelle du traitement est devenue la nouvelle norme
L’étude FLAIR a évalué un traitement individuel par ibrutinib-vénétoclax en fonction de la maladie résiduelle mesurable (MRD) par rapport au schéma thérapeutique standard par FCR (fludarabine, cyclophosphamide, rituximab).1 L’étude a inclus 523 patient·es en bonne santé âgé·es de ≤75 ans et atteint·es de LLC naïf·ves de traitement. Le critère d’évaluation primaire de l’étude était la survie sans progression (PFS).
La durée du traitement par ibrutinib plus vénétoclax a été guidée individuellement par la réponse de la MRD. Si la négativité de la MRD, définie comme <1 cellule sur 104 cellules, était constatée dans le sang périphérique des participant·es à l’étude à trois mois d’intervalle et confirmée dans le sang et la moelle osseuse trois mois plus tard, on a supposé une rémission potentielle et le traitement a été arrêté.
En comparant les deux bras de l’étude, on a observé, avec une durée médiane de suivi de 43,7 mois, un taux de PFS à 3 ans de 97,2% sous ibrutinib plus vénétoclax par rapport à 76,8% sous FCR. Le risque de progression a été réduit de 87%dans le bras de traitement par rapport au bras de contrôle (HR: 0,13; IC à 95%: 0,07–0,24; p<0,0001). En ce qui concerne la survie globale (OS), le risque de décès a été réduit de 69% (HR: 0,31; IC à 95%: 0,15–0,67; p<0,005). Après trois ans, 9 patient·es (2%) étaient décédé·es dans le bras sous ibrutinib-vénectoclax par rapport à 25 (7,0%) dans celui sous FCR. Un avantage du traitement individuel a été observé pour tous les sous-groupes biologiques, la PFS étant plus longue dans les sous-groupes présentant un statut non muté des IGHV, une délétion 11q, une trisomie 12 et une délétion 13q par rapport aux autres sous-groupes.
Les auteur·es ont conclu que les bons résultats obtenus sous ibrutinib plus vénétoclax indiquaient qu’une durée de traitement adaptée à la réponse individuelle de la MRD pouvaient maximiser le succès thérapeutique.
Données à 6 ans de l’étude ELEVATE-TN en faveur de l’acalabrutinib en tant que traitement de première intention
L’acalabrutinib est un BTKi de deuxième génération qui, sur la base des résultats de l’étude de phase III ELEVATE-TN, a été approuvé pour le traitement des patient·es atteint·es de LLC naïf·ves de traitement en association avec l’obinutuzumab ou en monothérapie. Lors du congrès de l’ASH, une mise à jour a pu être présentée avec des résultats obtenus après une durée médiane de suivi de 74,5 mois.2
L’étude de phase III ELEVATE-TN a comparé l’acalabrutinib plus obinutuzumab (n=179) avec l’obinutuzumab plus chlorambucil (n=177). Dans un troisième bras de l’étude, l’acalabrutinib a été utilisé en monothérapie (n=179). Le critère d’évaluation primaire était la PFS. Le passage du bras de contrôle au bras sous acalabrutinib en monothérapie était autorisé et a concerné 79 patient·es (44,6%).
Après 72 mois, 78% des patient·es (acalabrutinib-obinutuzumab) par rapport à 62% (acalabrutinib en monothérapie) et 17% (bras de contrôle) n’ont montré aucune progression. La PFS médiane était de 27,8 mois sous obinutuzumab plus chlorambucil et n’était pas encore atteinte dans les bras sous acalabrutinib. Lorsque les patient·es de l’un des bras sous acalabrutinib présentaient une rémission complète (CR/CRi), le risque de progression ou de décès était réduit de 77% par rapport à celui des patient·es ne présentant aucune CR/CRi (HR:0,23; IC à 95%: 0,12–0,42; p<0,0001). Des taux de CR plus élevés ont été observés sous acalabrutinib en tant que traitement combiné par rapport à sous acalabrutinib en monothérapie. Alors que le statut des IGHV a influencé de manière significative le pronostic des patient·es dans le bras sous obinutuzumab-chlorambucil, aucune différence significative n’a été constatée dans les bras sous acalabrutinib en ce qui concerne le gène IGHV non muté ou muté. Une influence de la mutation TP53 sur le pronostic a uniquement été observée sous acalabrutinib plus obinutuzumab. L’OS était significativement différente sous acalabrutinib plus obinutuzumab par rapport à celle sous obinutuzumab plus chlorambucil (HR: 0,62; IC à 95%: 0,39–0,97; p=0,035). Le taux d’OS à 72 mois était de 87% par rapport à 79% et 80%.
Après une durée de suivi d’environ six ans, les auteur·es ont conclu que l’efficacité et la sécurité de l’acalabrutinib plus obinutuzumab ainsi que de l’acalabrutinib en monothérapie avaient été confirmées. La OS médiane n’a été atteinte dans aucun des bras de l’étude.
Ibrutinib plus vénétoclax par rapport à chlorambucil plus obinutuzumab
L’étude de phase III GLOW a comparé les schémas thérapeutiques ibrutinib plus vénétoclax (12 cycles) et chlorambucil plus obinutuzumab (6 cycles). Les patient·es inclus·es étaient atteint·es de LLC, naïf·ves de traitement, âgé·es de ≥65 ans ou <65 ans, présentaient des comorbidités, mais aucune mutation TP53 connue. Le critère d’évaluation primaire était la PFS. Lors du congrès de l’ASH, des résultats obtenus après une durée médiane de suivi de 57,3 mois ont été présentés.3
Une durée de suivi plus longue a confirmé l’avantage en termes de PFS de l’association ibrutinib plus vénétoclax (HR: 0,26; IC à 95%: 0,17–0,38; p<0,0001). Après 54 mois, 66,5% des patient·es par rapport à 19,5% étaient en vie et ne présentaient aucune progression de la maladie. La supériorité de l’association ibrutinib plus vénétoclax par rapport à l’association chlorambucil plus obinutuzumab a été démontrée indépendamment du statut mutationnel des IGHV au début de l’étude et/ou du statut de la MRD trois mois après la fin du traitement.
Trois mois après le traitement par ibrutinib plus vénétoclax, une MRD non détectable (uMRD) a été observée chez 54,7% des patient·es par rapport à 32,1% trois ans après le traitement. Les taux d’OS à 42 et 54 mois étaient respectivement de 87,5% et 84,5% dans le bras sous ibrutinib-vénétoclax par rapport à 77,6% et 63,7% dans celui sous chlorambucil-obinutuzumab. Au moment de la collecte des données, 19 décès par rapport à 39 étaient survenus. Les infections post-thérapeutiques ont entraîné le décès de 3 patient·es dans le bras sous ibrutinib-venetoclax par rapport à 13 dans celui sous chlorambucil-obinutuzumab, et les affections malignes primaires secondaires le décès de 2 patient·es par rapport à 7.
Le délai jusqu’au traitement suivant (TTNT: HR: 0,18; IC à 95%: 0,10–0,35; p<0,0001) et la période sans traitement (TFS: HR: 0,30; IC à 95%: 0,19–0,47; p<0,0001) ont été significativement prolongés sous ibrutinib plus vénétoclax par rapport à ceux sous chlorambucil plus obinutuzumab.
Conclusion des auteur·es: Une durée de suivi plus longue a confirmé l’association ibrutinib-venetoclax avec une durée de traitement fixe par rapport à l’association chlorambucil plus obinutuzumab. Le risque de devoir recourir à un traitement de deuxième intention a été réduit de 82%.
La rédaction de notre compte rendu ASH Newsroom a été réalisée avec le soutien financier de GlaxoSmithKline AG et d’Incyte Biosciences Austria GmbH, sans aucune influence des sponsors sur le contenu.
Source:
65e congrès annuel de l’American Society of Hematology, 9–12 décembre 2023, San Diego, Californie, et en ligne
Littérature:
1 Hillmen P et al.: ASH 2023; Abstr. #631 2 Sharman JP et al.: ASH 2023; Abstr. #636 3 Follows G et al.: ASH 2023; Abstr. #634
Das könnte Sie auch interessieren:
Normes thérapeutiques: développements actuels
Les standards thérapeutiques du lymphome à cellules du manteau (MCL) sont actuellement en pleine évolution: récemment, des inhibiteurs de la tyrosine kinase de Bruton (BTKi) ont été ...
Des avancées modifiant la pratique et des signaux déterminants pour l’avenir
Le congrès SOHC 2025 a illustré de manière impressionnante la diversité des dynamiques actuelles du progrès thérapeutique en oncologie. Le programme de la session «Highlights of the Year ...
«Mind Body Medicine»: un programme en oncologie ambulatoire
La «Mind Body Medicine» (MBM), composante de l’oncologie intégrative, est un concept qui relie le corps et l’esprit et transmet des compétences d’auto-prise en charge. Dans le cadre du « ...


